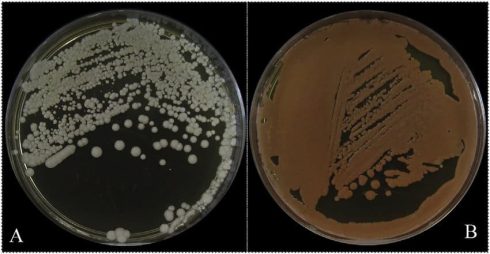
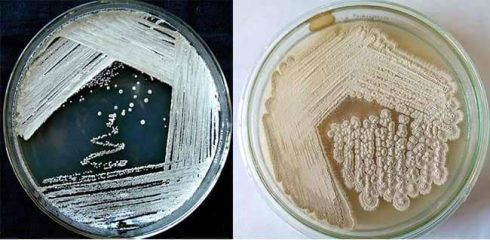
آگار SCA
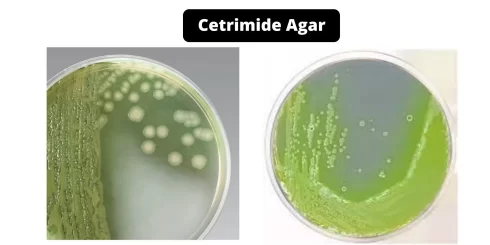
آگار ستریماید
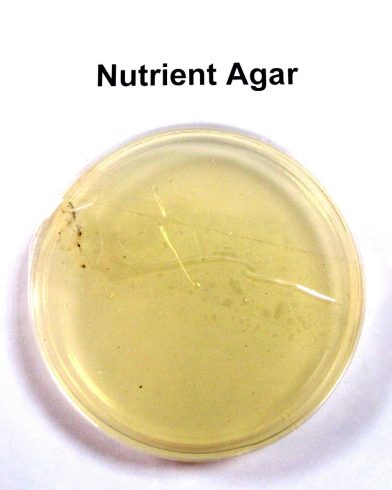
نوترینت آگار

آرشیو دسته بندی: ابزار و وسایل آزمایشگاهی شامل، محلول ها کیت ها
آگار CLED: ترکیب، اصول، روش تهیه، نتایج و کاربرد
مقدمهای بر آگار CLED محیط کشت کمبود سیستین-لاکتوز- الکترولیت (CLED) که ابتدا توسط Sandys توصیف[بیشتر بخوانید]
مانیتول سالت آگار (محیط کشت MSA): ترکیبات، کاربرد، تهیه
مقدمهای بر محیط کشت مانیتول سالت آگار آگار MSA به عنوان یک محیط انتخابی و[بیشتر بخوانید]
چراغ بونزن: عملکرد، قطعات، انواع، دستورالعمل و کاربرد
چراغ بونزن نوعی چراغ گازی است که شعلهای ایمن، بدون دود، داغ و بدون نور[بیشتر بخوانید]
8 دیدگاه
سابورو دکستروز آگار (SDA): ترکیب، اساس، کاربرد، تهیه و مورفولوژی کلنی
سابورو دکستروز آگار (SDA) برای جداسازی، کشت و نگهداری گونههای غیر بیماریزا و بیماریزای قارچها[بیشتر بخوانید]
آگار SCA (نشاسته کازئین آگار): ترکیب، کاربردها، آماده سازی و تفسیر
مقدمهای بر آگار SCA (نشاسته کازئین آگار) نشاسته کازئین آگار (Starch Casein Agar) یا آگار[بیشتر بخوانید]
آگار Bird Seed برای جداسازی کریپتوکوکوس نئوفورمانس
مقدمهای بر آگار Bird Seed آگار Bird Seed یک محیط جامد است که برای جداسازی[بیشتر بخوانید]
آگار ستریماید (Cetrimide Agar): ترکیب، اساس، کاربردها، آماده سازی و مورفولوژی کلنی
مقدمهای بر آگار ستریماید آگار ستریماید یک محیط انتخابی و افتراقی است که برای جداسازی[بیشتر بخوانید]
2 دیدگاه
رنگ های رومانوفسکی: اصول، انواع، کاربردها
رنگ های رومانوفسکی چیست؟ رنگ های رومانوفسکی رنگ هایی هستند که در مطالعات هماتولوژی و[بیشتر بخوانید]
کلیگلر آیرون آگار (Kligler’s Iron Agar (KIA)) اصول، رویه، نتایج
مقدمهای بر کلیگلر آیرون آگار کلیگلر آیرون آگار برای تشخیص تخمیر کربوهیدرات استفاده میشود. واکنشهای[بیشتر بخوانید]
2 دیدگاه
EMB آگار: فرمول، اصول، آماده سازی، نتایج و موارد استفاده
درباره EMB آگار ائوزین متیلن بلو آگار (Eosin Methylene Blue (EMB) agar) یک محیط میکروبیولوژیکی[بیشتر بخوانید]
6 دیدگاه
نوترینت آگار: ترکیبات، کاربردها و طرز تهیه
درباره نوترینت آگار (آگار مغذی) آگار مغذی (نوترینت آگار) یک محیط مغذی با هدف عمومی[بیشتر بخوانید]
بنزن چیست؟
بنزن یک ماده شیمیایی است که در دمای اتاق مایعی بی رنگ یا زرد[بیشتر بخوانید]
تریپسین چیست؟
یک آنزیم پروتئولیتیک برای درمان التهاب و زخم تریپسین یکی از چندین آنزیم پروتئولیتیک است[بیشتر بخوانید]
1 دیدگاه
کیموتریپسین چیست؟
به هضم و ترمیم زخم کمک میکند و التهاب را کاهش میدهد کیموتریپسین یک[بیشتر بخوانید]
5 دیدگاه
اهمیت بافر Tris-EDTA (TE) در استخراج DNA
سیستم بافر TE (Tris-EDTA) از Tris و EDTA تشکیل شده است و نقش مهمی در[بیشتر بخوانید]
8 دیدگاه
سرم جنین گاوی چه کاری انجام میدهد؟
سرم جنین گاوی (FBS) محصول جانبی بهدستآمده از گاو در صنعت گوشت گاو است[بیشتر بخوانید]
کریستال ویوله (ویولت)
مقدمه کریستال ویوله (ویولت) یک نمک کلرید آلی است که متعلق به رنگهای قلیایی از[بیشتر بخوانید]
10 دیدگاه
شیشه قهوه ای ضد نور آزمایشگاهی
اهمیت شیشه قهوه ای ضد نور آزمایشگاهی بشر (Beakers)، ظروف پتری (Petri )، ویال (vials)، بورت[بیشتر بخوانید]
رنگ سافرانین: ویژگی، روش انجام و کاربردها
مقدمه رنگ سافرانین سافرانین یک رنگ کاتیونی است که در بافت شناسی و سیتولوژی برای[بیشتر بخوانید]
کلاژناز چیست؟
مقدمهای بر کلاژناز کلاژناز ها آنزیم هایی هستند که پیوندهای پپتیدی موجود در کلاژن را[بیشتر بخوانید]
تریس
تریس تریس هیدروکسی متیل آمینو متان، همچنین به عنوان ترومتامین یا THAMدر پزشکی شناخته میشود،[بیشتر بخوانید]
2 دیدگاه